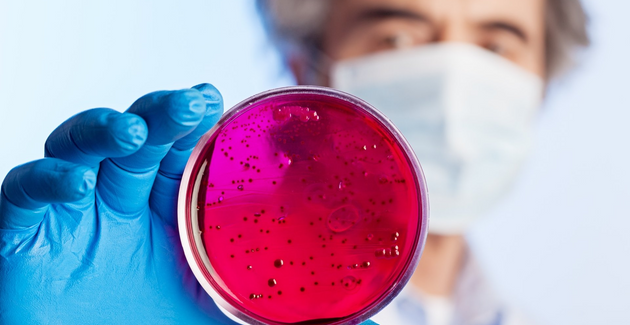

Nuestras Soluciones
Ofrecen ventajas competitivas y ahorro
Industria Papelera

Antiespumantes
Nuestros productos mantienen un nivel de espuma estable es sus procesos continuos generando un bajo consumo de agua fresca.

Control de Contaminantes
Estos productos dispersan eficientemente los contaminantes presentes en la materia prima tales como tintas, recubrimientos y adhesivos.
Control Microbiológico
Los microorganismos presentes pueden ser bacterias aeróbicas, anaeróbicas, hongos, levaduras, sulfato reductoras que producen mal olor, Salmonela y E.Coli.

Agentes Release / Resina
En el proceso de fabricación de papel higiénico es necesario contar con un agente químico que permita un fácil desprendimiento de la hoja en el secador yankee, el cual permita incrementar la productividad de la máquina,

Incremento de Resistencia del Papel
Nuestros productos aumentan las resistencias en la hoja de papel, tales como: RCT, CFC y CMT primordialmente.

Limpieza de Vestiduras
Los contaminantes orgánicos e inorgánicos que se depositan en las vestiduras en la máquina de papel, originan pérdidas de permeabilidad en las mismas, provocando problemas de calidad en el papel y paros constantes de máquina para limpieza.

Repulpeo de RH
Los papeles fabricados con resistencia en húmedo no son amigables con el medio ambiente, ya que no son ni biodegradables, ni compostables y difícilmente repulpables.
Tratamiento de Aguas

Tecnología de Renovación Molecular TRM
Es una tecnología avanzada e innovadora que permite cumplir las normas establecidas de reúso y descarga que logra importantes ahorros en el proceso de tratamiento de aguas residuales con al menos un 15% de reducción en costos operativos y tiempos de tratamiento muy cortos.
Industria Papelera

Antiespumantes
Nuestros productos mantienen un nivel de espuma estable es sus procesos continuos generando un bajo consumo de agua fresca.

Control de Contaminantes
Estos productos dispersan eficientemente los contaminantes presentes en la materia prima tales como tintas, recubrimientos y adhesivos.

Control Microbiológico
Los microorganismos presentes pueden ser bacterias aeróbicas, anaeróbicas, hongos, levaduras, sulfato reductoras que producen mal olor, Salmonela y E.Coli.

Agentes Release / Resina
En el proceso de fabricación de papel higiénico es necesario contar con un agente químico que permita un fácil desprendimiento de la hoja en el secador yankee, el cual permita incrementar la productividad de la máquina,

Incremento de Resistencia del Papel
Nuestros productos aumentan las resistencias en la hoja de papel, tales como: RCT, CFC y CMT primordialmente.

Limpieza de Vestiduras
Los contaminantes orgánicos e inorgánicos que se depositan en las vestiduras en la máquina de papel, originan pérdidas de permeabilidad en las mismas, provocando problemas de calidad en el papel y paros constantes de máquina para limpieza.

Repulpeo de RH
Los papeles fabricados con resistencia en húmedo no son amigables con el medio ambiente, ya que no son ni biodegradables, ni compostables y difícilmente repulpables.
Tratamiento de Aguas









